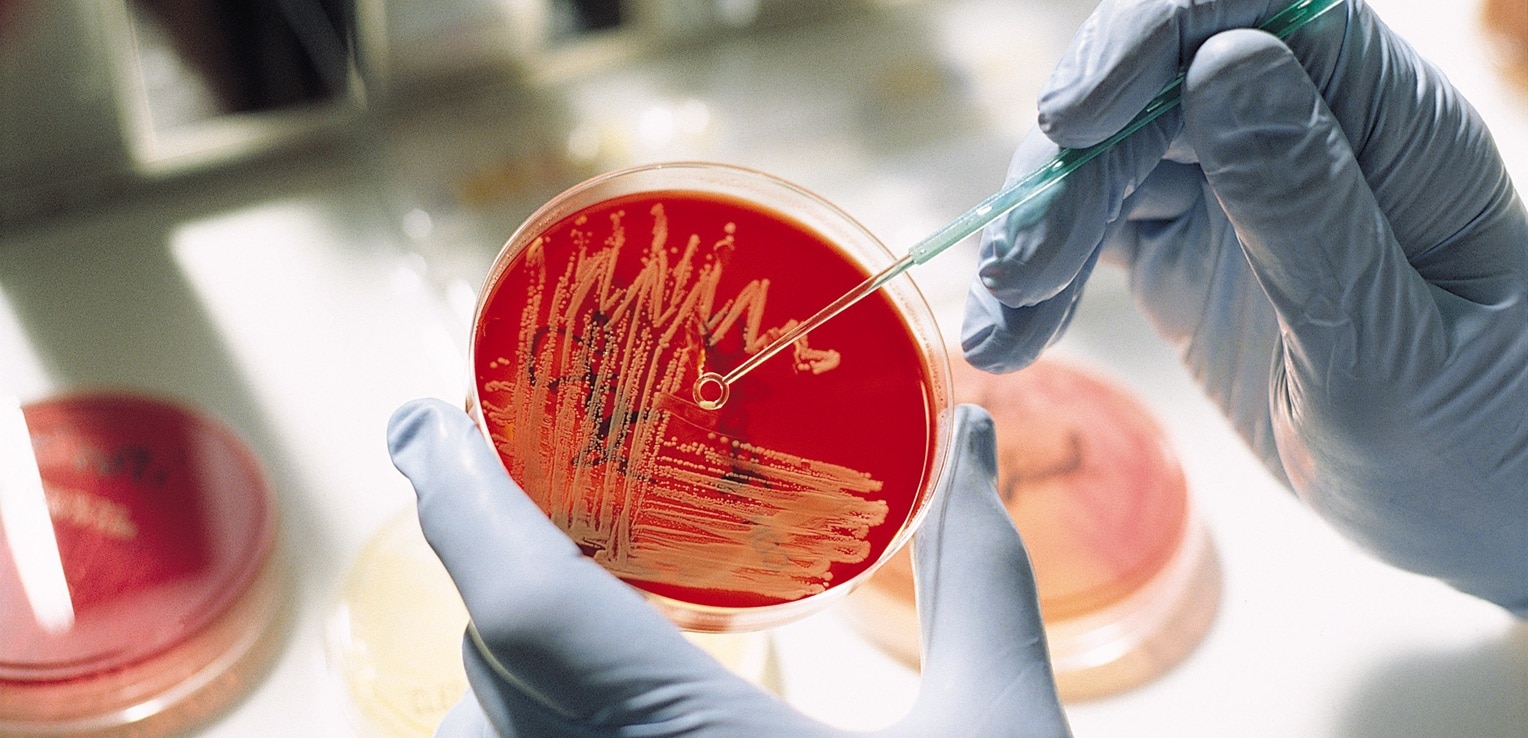

BD BBL™ prepared plated media enables the isolation of microorganisms from samples or specimens. Ready for immediate use, they are routinely available in several types of Petri-style dishes, containing a variety of media.
Many media manufacturers purchase petri dished and dehydrated culture media components necessary to produce their products from outside vendors. History has shown us that it is optimal to have control of your raw materials. As such, we have integrated raw material manufacturing into our operations to maintain control over the quality of ingredients used in our products. Our associates produce all of the petri dishes. The dehydrated culture media is made in a state-of-the-art facility in Sparks, Maryland. It is sold as a finished product and used in the prepared media formulations we manufacture.
Our facilities operate under full cGMP standards, are FDA-inspected, and ISO 9001 certified. At our Maryland site, we uphold rigorous procedures and invest significantly to ensure every product lot meets the highest standards of quality and integrity.